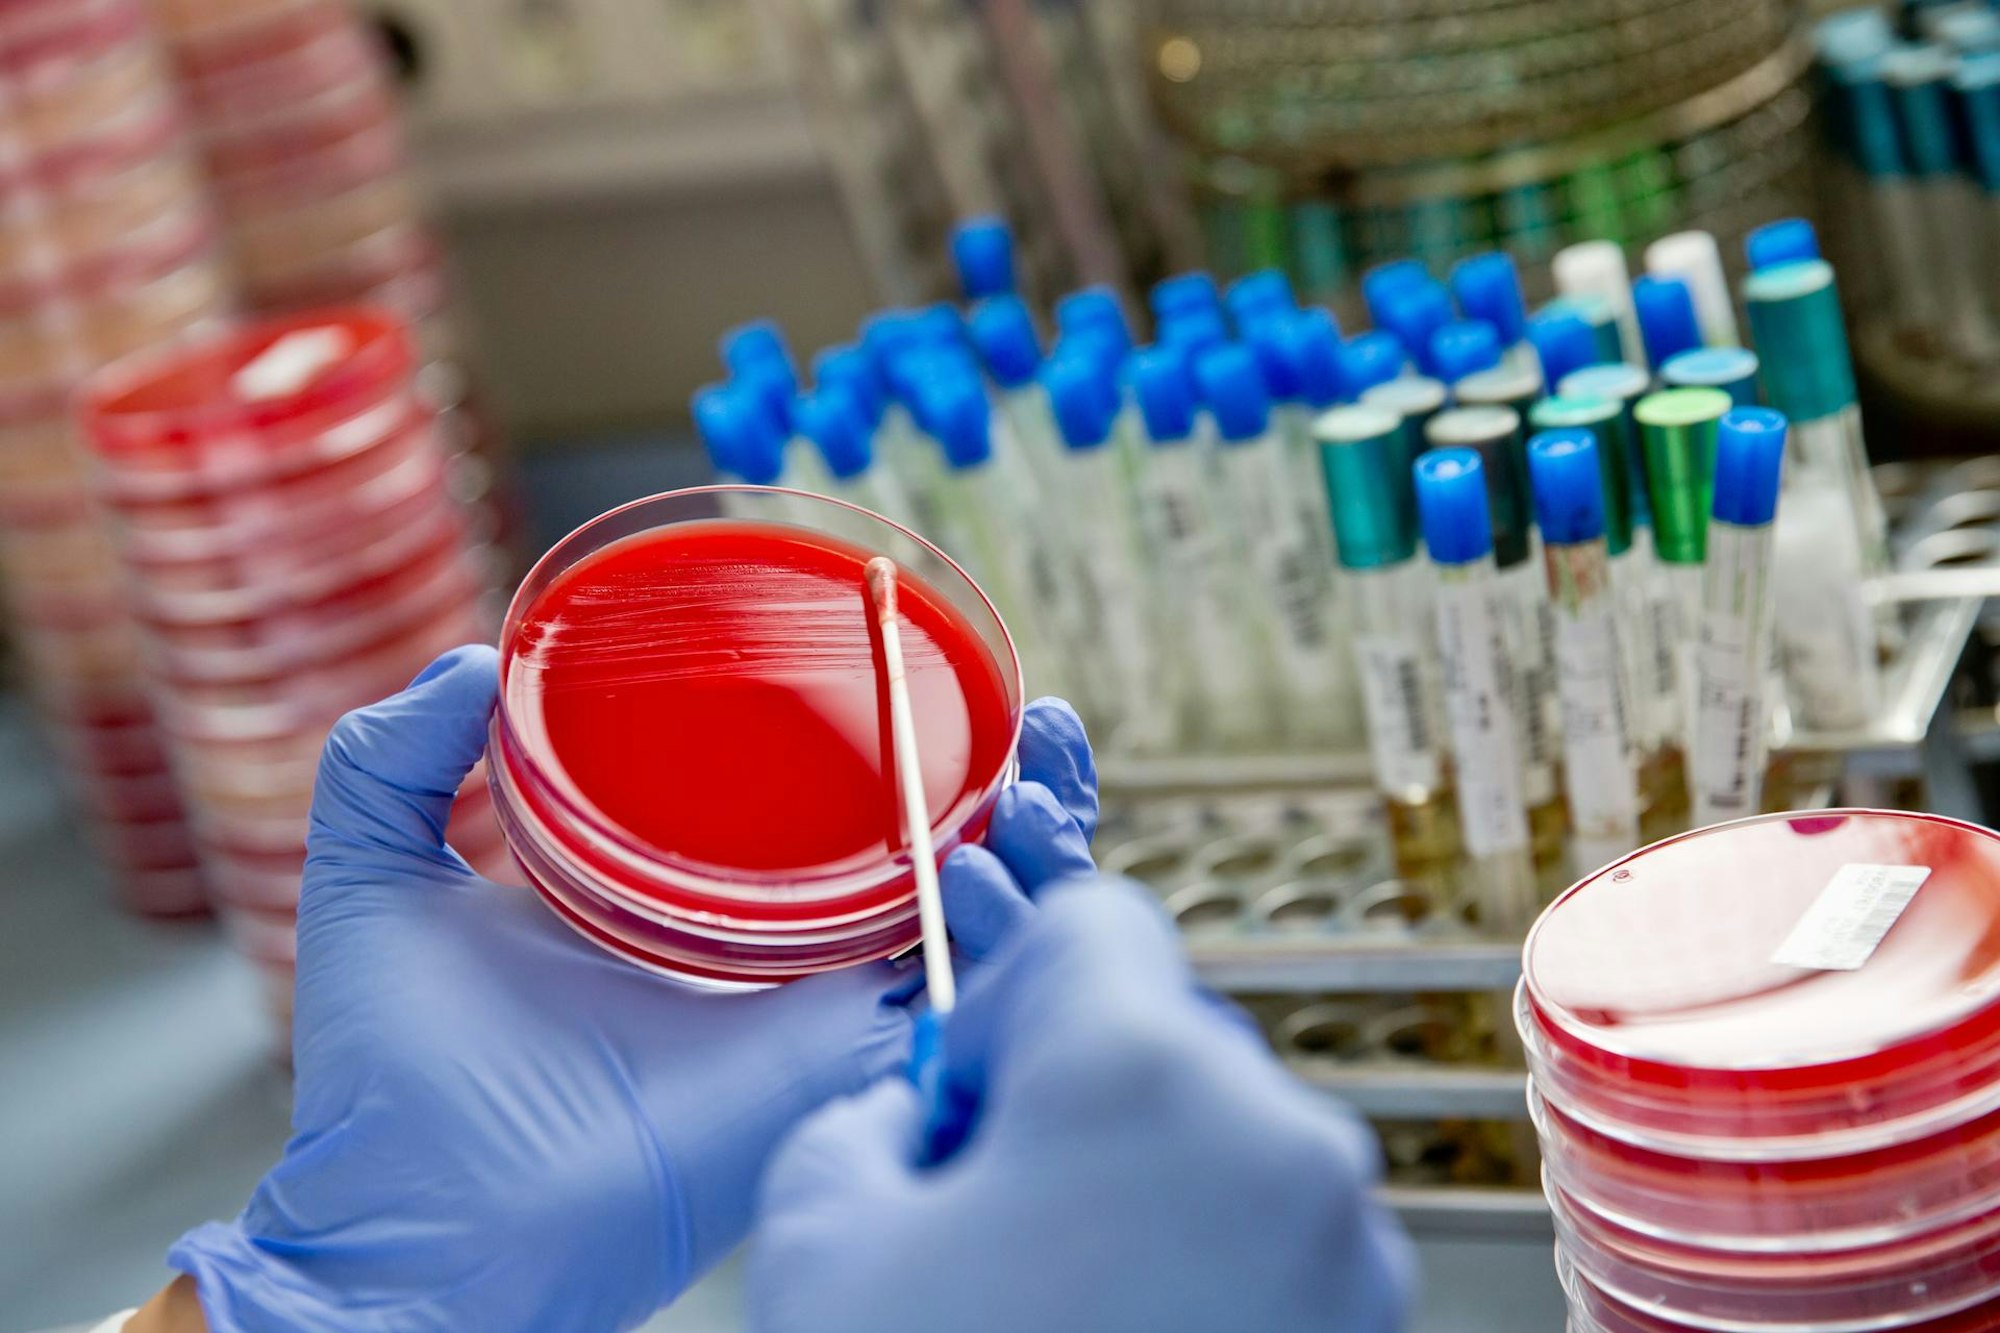
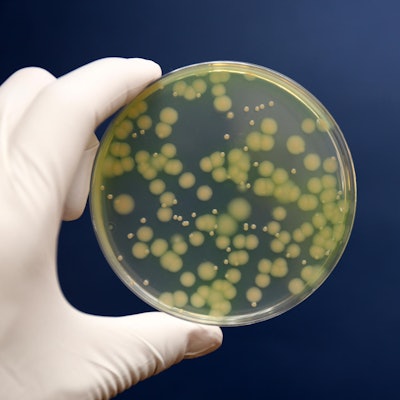

- Wenn der Rücken schmerzt oder das Knie zwickt, sollen in vielen Fällen Injektionen helfen.
- Doch die Eingriffe sind riskant – wie aktuell auch die massenhafte Keim-Übertragung in einer Kölner Praxis zeigt.
- Es ist nicht der erste Fall. Und der mögliche Ärger beginnt erst, wenn der Betroffene die Praxis längst verlassen hat.
Köln – So ein Fall lässt einem Arzt keine Ruhe. Das ist aus April Pettits Rechtfertigung im „New England Journal of Medicine“ herauszulesen. Als sich ein etwa 50-jähriger Mann 2012 in der Uniklinik im amerikanischen Nashville vorstellte, sah für die Infektionsexpertin alles nach einer klassischen Hirnhautentzündung aus: Kopf- und Nackenschmerzen, dazu Übelkeit, die zahlreichen Abwehrzellen in der Gehirnflüssigkeit sprachen ebenfalls für die Diagnose einer bakteriellen Meningitis. Ein Routinefall dachten die Ärzte und entließen ihren Patienten mit einer Packung Antibiotika. Eine Woche später hatte der Mann noch heftigere Kopfschmerzen. Die Antibiotika hatten nichts bewirkt, ein Pilz war die unerwartete Ursache der Symptome. Drei Wochen später war der Patient tot.
Wie war der Keim Aspergillus in die Gehirnflüssigkeit gekommen? Wie hatte er ein Abwehrsystem überwunden, das im Normalfall locker mit ihm fertig wird? Die Befragung der Verwandten ließen bei April Pettit alle Alarmglocken klingeln. Ihr Patient hatte zuvor wegen Schmerzen Cortisonspritzen in den Rücken bekommen. Patient Nummer eins sollten weitere 290 Amerikaner mit Infektionen von Gehirn, Rückenmark und Umgebung folgen – und 61 Tote. Die Lösung in den Spritzen war verseucht. Viele machten aber nicht nur den Pilz für die Erkrankungen verantwortlich. Ihrer Meinung nach war schon die Cortisonspritze selbst die Grundvoraussetzung der Katastrophe.
Das könnte Sie auch interessieren:
Gefährliche Keime können sich ihren Weg bahnen
Denn eine der markantesten Eigenschaften des körpereigenen Hormons Cortisol und seiner künstlichen Ableger ist ihre Wirkung auf das menschliche Immunsystem. Nach einer solchen Injektion sinkt nicht nur die Zahl der Abwehrzellen, diese sind auch träger und kommunizieren weniger über Hormone.
All das kann nicht nur gefährlichen Keimen den Weg bahnen, es macht auch die Anziehungskraft des Medikaments aus. Denn mit dem Immunsystem unterdrücken die Glukokortikoide oder Steroide, wie der Fachmann die Wirkstoffgruppe nennt, auch schmerzhafte Abwehrreaktionen wie Entzündungen. Und diese spielen gerade bei vielen orthopädischen Krankheiten eine Rolle: Bei einem Bandscheibenvorfall etwa sorgen sie dafür, dass der geschwollene Nerv im verengten Knochenkanal noch weniger Platz hat. Auch ein verschlissenes Gelenk macht sich besonders unangenehm bemerkbar, wenn es mit einer Entzündung reagiert. Cortison, so das Kalkül der Orthopäden, ist deshalb in der Lage, all diese Symptome zu lindern und den Patienten zufriedenzustellen.
Mindestens 28 Menschen sollen sich mit den Keimen infiziert haben (Symbolbild).
Copyright: picture alliance / Daniel Karman
Nicht nur Amerikaner zahlen dafür allerdings manchmal einen hohen Preis. Kurz vor dem beschriebenen Ausbruch in den USA berichteten die Orthopäden Christian Holland und Christina Otto-Lambertz 2012 im Deutschen Ärzteblatt beispielsweise über den Fall einer 74-jährigen Deutschen. Ein Neurochirurg hatte ihr mehrfach Cortison in den Rücken gespritzt. Zwei Tage nach der letzten Injektion tauchte sie mit gelähmten Beinen in der Notfallaufnahme auf. Mit der Nadel waren auch Bakterien in den Körper gedrungen und hatten in Rückenmarkkanal und Umgebung eitrige Abszesse gebildet. Diesmal hatte es gar keine gepanschte Injektionsflüssigkeit gebraucht, die Erreger hatten die Spritze nur als Einfallstor benutzt.„Egal, wie sauber wir als Orthopäden desinfizieren und spritzen“, erklärt Otto-Lambertz, Oberärztin an der Uniklinik Köln, „wir können auf der Haut immer nur eine Verminderung der Bakterienzahl erreichen.“ Auf und in der Haut leben so viele Keime, dass sie selbst mit der gründlichsten Vorbereitung nicht zu beseitigen sind. „Die Gefahr, Erreger mit der Injektion in die Tiefe zu verschleppen, ist sehr hoch“, sagt die Expertin im Interview 2017. Das Steroid kann die entscheidende Lücke in die Körperabwehr reißen.
Nur ein Bruchteil der Patienten wendet sich an einen Arzt
278-mal hatten Gutachter und Schlichter der deutschen Ärztekammer zwischen 2005 und 2009 mit derartigen Fällen zu tun. Und an sie wendet sich nur ein Bruchteil der Patienten. Christian Holland und Christina Otto-Lambertz hielten es deshalb für angebracht, die Kollegen zu mehr Vorsicht aufzurufen. Denn viele Mediziner würden zu häufig und zu schnell zur Spritze greifen. Und dies oft nicht fachgerecht: „Es besteht die Situation einer nicht vertretbaren Gefährdung der Patienten“, so seinerzeit das Fazit der Autoren.
Daran hat sich in der Zwischenzeit leider wenig geändert. Wie oft Ärzte in Knie, Sehnen und Rücken spritzen, wird laut Kassenärztlicher Bundesvereinigung zwar nirgendwo erfasst. Festgehalten ist jedoch die Zahl der Tagesdosen an Cortisonpräparaten, die niedergelassene Orthopäden als Hauptnutzer zu Injektions-Zwecken in Apotheken bestellen. Sie hat zwischen 2009 und 2016 in Deutschland um rund ein Drittel zugenommen.
Verdoppelt haben sich im vergangenen Jahrzehnt auch die Bandscheiben-Infektionen, bei denen Spritzen neben Operationen als Hauptauslöser gelten. Bei bis zu jeder 1000. Rückeninjektion, schätzt man, ist mit einer solchen oder ähnlich schweren Infektion zu rechnen. Die Folgen können Rückenmark-Abszess, Gehirnhautentzündung oder Querschnittslähmung sein. Mit jeder 50. bis 100. Spritze, so andere Studien, dringen Bakterien mit weniger schweren Folgen Richtung Rückenmark vor.
Auch am Kniegelenk können die Folgen solcher Spritzen verheerend sein: Der Orthopäde Shai Shemesh hat sechs solcher Patienten behandelt. Alle wurden operiert, berichtete er 2011 im Journal der israelischen Ärzte-Organisation, die Mehrzahl sogar mehrfach, einer verlor sogar das Bein. Bislang rechnen die Orthopäden nach schwammigen 3000 bis 50 000 Injektionen mit solchen Komplikationen. Angesichts von geschätzten zwanzig Millionen solcher Spritzen pro Jahr würde sich das allein in Deutschland auf bis zu 7000 Betroffene addieren.In den Krankenhausstatistiken ist in den letzten zehn Jahren jedoch parallel zu der Zunahme der Cortison-Injektionen auch die Zahl solcher Gelenkinfektionen um dreißig Prozent angestiegen. „Eine Spritze ins Knie ist keine harmlose Prozedur und sollte nicht leichtfertig vorgenommen werden“, warnt Shemesh, „vor allem, weil ihr langfristiger Nutzen fraglich ist.“ Letzteres konnten zum Beispiel 2017 Rheumatologen vom Bostoner Tufts Medical Center in der Fachzeitung „Jama“ belegen. Sie hatten 140 Arthrose-Patienten zwei Jahre lang entweder regelmäßig Cortison oder Wasser ins Knie gespritzt. Das Ergebnis: An den Schmerzen hatte das Cortison langfristig nichts geändert. Der Knorpelverlust war dagegen bei den mit dem echten Medikament behandelten Probanden ein Stück weiter fortgeschritten.
Erschütternde Bilanz bei Rückenleiden
Bei Rückenleiden ist die Bilanz noch ernüchternder: Jan Hildebrandt, einst Chef der Schmerzmedizin der Uniklinik Göttingen, war 2011 an einer Cochrane-Analyse beteiligt. Sinnvoll erschien ihm und seinen Kollegen eine solche Spritze nur unter einer einzigen Bedingung: Wenn sich bei einem akuten Bandscheibenvorfall der gequetschte Nerv entzündet und der Schmerz in Arme oder Beine zieht. Bei chronischen Rückenleiden dagegen, schreiben sie, sei eine Spritze in der Regel die falsche Wahl. Dies gilt, egal, ob sie in Wirbelgelenke, Muskulatur oder als „epidurale Injektion“ auf die Dura, die Haut des Rückenmarks, gesetzt wird: „Die meisten Kortikoidinjektionen“, sagt Hildebrandt, „sind überflüssig und wirkungslos und werden oft auf die falsche Weise gegeben.“ Ohne Gegenkontrolle auf dem Röntgenschirm, so lässt sich belegen, zielt die Mehrzahl der Ärzte regelmäßig daneben. Zwischen Tür und Angel, so der Experte, lasse sich eine Spritze nicht geben – allein schon wegen der nötigen Sterilität.Eine weitere Nebenwirkung bekommt Martin Reincke in seiner Ambulanz an der Ludwig-Maximilians-Universität München in den letzten Jahren immer häufiger zu sehen: das Gesicht aufgedunsen und gerötet; Menschen, die kaum noch aus dem Stuhl hochkommen, infektanfällig sind, hohen Blutdruck und schlecht verheilende Wunden haben – typische Zeichen eines Cushing-Syndroms, eines Glukokortikoid-Überschusses im Körper. Das Steroid, erklärt der Endokrinologe, wird nach den Injektionen über Tage und Wochen aus Gelenk oder Wirbelsäule freigesetzt, sickert in die Blutbahn und verteilt sich im Körper. Dort führt das Stresshormon zu einem Abbau von Knochen und Muskeln. Es treibt den Zuckerspiegel hoch, macht das Gehirn reaktionsbereit – bis zu Angstattacken und Psychosen.
Trotzdem schwören viele Betroffene und Ärzte auf diese Medikamente. Warum? Weil eine Spritze, wie der Bostoner Rheumatologe David Felson ( Harvard-Universität) sagt, eben doch manchen Menschen mit Gelenkverschleiß über akute Schmerzen hinweghelfe. „Aber sie sollte keine Dauerlösung sein.“ Selbst nach einer Anwendung am Rücken wird der Patient nach einer Cortison-Injektion wahrscheinlich zufriedener die Praxis verlassen. Auch wenn man vermeintliche Steroid-Spritzen ins Knie mit Wasser füllt, zeigen Studien, geht es jedem Dritten danach besser – so groß ist der Placeboeffekt.
Das sei die gefährliche Verführungskraft des Cortisons, so Reincke. Gespritzt mache es im ersten Moment Arzt und Patient fast immer zufrieden – der mögliche Ärger beginnt erst, wenn der Betroffene die Praxis längst verlassen hat.